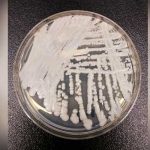
Aparece nuevo hongo resistente en hospitales de EEUU

Etiqueta: infeccion
Hombre muere por nadar después de hacerse un tatuaje
Un hombre de 31 años de edad, tres días después de hacerse un tatuaje en la pierna derecha fue a nadar al Golfo de...
¿Por qué sale acné en ciertas partes del cuerpo? Descúbrelo aquí
Todos en algún momento de nuestras vidas hemos sido afectados por la presencia del acné en nuestro cuerpo y hemos tenido que hacer cientos...
Esta es la terrible realidad detrás de los apretujones a los gatos
Científicos estadounidenses tienen malas noticias para los que aman abrazar y apretujar a adorables e indefensos gatitos. El problema de realizar esta aparentemente inocua...
Aparece nuevo hongo resistente en hospitales de EEUU
Un hongo resistente a fármacos está apareciendo como una nueva amenaza en hospitales de Estados Unidos, principalmente en Nueva York y Nueva Jersey.
Tras ser...
Elton John contrajo una infección «potencialmente mortal» tras la gira en Sudamérica
El músico pop británico Elton John se recupera tras padecer una infección "potencialmente mortal" contraída al término de una gira en Sudamérica, estuvo internado...
Descubren un nuevo escondite del VIH en el organismo humano
El virus de la inmunodeficiencia humana (VIH) es capaz de desasorrallarse en otro tipo célula del sistema inmunitario diferente al de los linfocitos T....
Condenan a sujeto por violar a bebé en El Salvador
Autoridades judiciales condenaron a un sujeto que abusó sexualmente a su hija de un año. El hecho sucedió el año pasado cuando la bebé...
Desarrollan en España tecnología para detectar más rápido el VIH
El Consejo Superior de Investigaciones Científicas (CSIC) de España patentó una novedosa tecnología que permitiría detectar el virus del VIH solo una semana después...